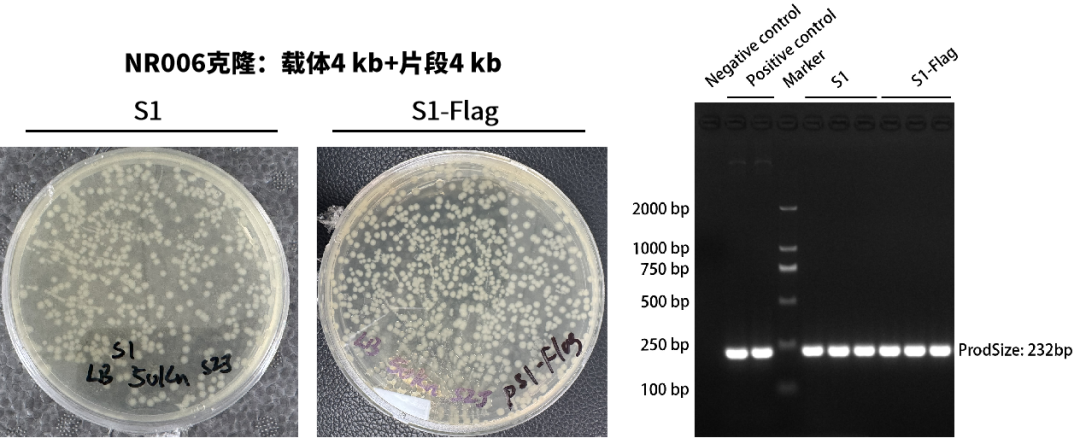
图片

您是否也有这样的困扰?
PCR扩增没问题,一到克隆就反复翻车
无缝克隆步骤不少,条件稍有偏差就失败
好不容易拿到阳性克隆,测序却发现突变
正因如此,越来越多实验室在选择试剂时,更倾向于“搭配成熟、表现稳定”的基因克隆CP——既能保证无缝克隆的成功率,又能兼顾扩增阶段的高保真性。由近岸蛋白推出的这对基因克隆CP(无缝克隆+高保真)被不少实验室反复选择,并收到了大量来自一线用户的真实反馈。让我们一起来看看吧~
高保真PCR(2×NovoFast HiFi Master Mix (Quick Load),Cat.No.: E185)
01 浙江大学
样本类型:质粒DNA
片段长度:1,578 bp
客户评价:效果很好!

02 北京某企业
样本类型:人基因组
片段长度:16,000 bp(大片段)
客户评价:目的片段长度是满足预期的!

03 中科院植物所
样本类型:cDNA
片段长度:1,000 bp-3,000 bp
扩增速度:快至1-5 s/kb
客户评价:非常快,质量挺好,方便!

04 中国海洋大学三亚海洋研究院
样本类型:质粒DNA
片段长度:11,289 bp
扩增速度:快至5 s/kb
结果:测序无突变
客户评价:总体来说效果很不错!

无缝克隆(NovoRec® plus One step PCR Cloning Kit 2.0,Cat.No.: NR006)
01 华中农业大学
连接个数:2片段(大载体+小片段)
克隆阳性率:100%

02 中科院广州生物医药与健康研究院
连接个数:2片段
连接速度:5 min快速连接
克隆阳性率:100%
客户评价:满意,较其他品牌缩短了反应时间,转化后菌落较多!
03 中国科学技术大学
连接个数:5片段
连接体系:低至10 μL
克隆阳性率:100%
客户评价:Good!

04 中科院深圳先进技术研究院
连接个数:2片段(大载体+小片段)
菌落数:优于其他品牌
克隆阳性率:100%
测序无突变
客户评价:非常好!

05 中国科学技术大学
连接个数:2片段
菌落数:优于其他品牌
克隆阳性率:100%
测序无突变
客户评价:重组效率高!

看完上述反馈你是否蠢蠢欲动,也想获得丝滑的基因克隆体验?
近岸蛋白明星产品倾情推荐
|
|
|
|
|
|
|
|
|
|
|
|
|
|
|
|
|
|
|
|
|
|
DM005 |
DNA Ladder 2000 |
500 μl |
|
DM006 |
DNA Ladder 2000 Plus |
500 μl |
|
|
DM021 |
|
|
|
|
DM028 |
DNA Ladder 5000 |
500 μl |
|
|
DM032 |
50bp DNA Ladder |
500 μl |
|
|
DM033 |
DNA Ladder 10000 |
500 μl |
|
|
核酸染料 |
E085 |
Nucleic Acid Gel GreenStain (in water, 10,000×) |
500 μl |
还可以扫描下方二维码0元申请试用哦~

高保真PCR E185

无缝克隆NR006
此外,为了满足大家的一站式基因克隆需求,还有基因克隆套装可供各位科研er们选择~


